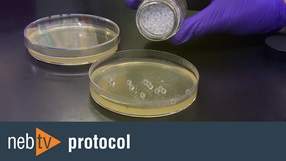

, cung cấp cho bạn những kiến thức và kỹ năng cần thiết để trở thành một người chơi cá cược thông minh và thành công.
Phân tích Cấu Trúc và Cách Đọc Tỷ Lệ Kèo Nhà Cái

Thế giới cá cược bóng đá đầy rẫy những con số và thuật ngữ chuyên môn, khiến nhiều người chơi mới cảm thấy bối rối. Hiểu rõ cấu trúc và cách đọc tỷ lệ kèo nhà cái
Trong thời đại công nghệ số, có rất nhiều công cụ và nguồn thông tin có thể giúp bạn soi kèo hiệu quả hơn. Tuy nhiên, bạn cần phải biết cách sử dụng chúng một cách thông minh và chọn lọc, tránh bị nhiễu loạn bởi quá nhiều thông tin.
Các trang web thống kê, phân tích dữ liệu bóng đá uy tín
Có rất nhiều trang web cung cấp thông tin thống kê và phân tích dữ liệu bóng đá, như Soccerway, Flashscore, Whoscored, v.v. Các trang web này cung cấp thông tin về phong độ của các đội, lịch sử đối đầu, đội hình dự kiến, thống kê bàn thắng, thẻ phạt, v.v.
Bạn có thể sử dụng các thông tin này để đánh giá sức mạnh của các đội, phân tích lối chơi, và dự đoán kết quả trận đấu. Tuy nhiên, bạn cần phải biết cách đọc và hiểu các con số thống kê, và không nên chỉ dựa vào chúng để đưa ra quyết định.
Sử dụng phần mềm hỗ trợ soi kèo - Lợi ích và rủi ro
Có một số phần mềm được quảng cáo là có thể giúp bạn soi kèo hiệu quả hơn. Các phần mềm này thường sử dụng các thuật toán phức tạp để phân tích dữ liệu và đưa ra dự đoán. Tuy nhiên, bạn cần phải cẩn thận khi sử dụng các phần mềm này, vì không phải phần mềm nào cũng đáng tin cậy.
Một số phần mềm có thể đưa ra những dự đoán sai lệch, hoặc thậm chí là lừa đảo. Do đó, bạn nên tìm hiểu kỹ về phần mềm trước khi sử dụng, và không nên chỉ dựa vào nó để đưa ra quyết định.
Cộng đồng cá cược và diễn đàn - Nguồn thông tin đa chiều
Tham gia các cộng đồng cá cược và diễn đàn trực tuyến có thể giúp bạn học hỏi kinh nghiệm từ những người chơi khác, trao đổi thông tin, và tìm kiếm những kèo cược thơm. Tuy nhiên, bạn cần phải cẩn thận với những thông tin được chia sẻ trên các diễn đàn này, vì không phải thông tin nào cũng chính xác và đáng tin cậy.
Hãy lựa chọn những diễn đàn uy tín, có nhiều thành viên tích cực, và có những người chơi có kinh nghiệm chia sẻ. Đừng tin vào những lời quảng cáo hoa mỹ hoặc những kèo cược "chắc chắn thắng".
Những Sai Lầm Thường Gặp và Cách Phòng Tránh
Ngay cả những người chơi cá cược có kinh nghiệm cũng có thể mắc phải những sai lầm. Biết được những sai lầm thường gặp và cách phòng tránh chúng có thể giúp bạn cải thiện tỷ lệ thắng cược của mình.
Bẫy tâm lý "hiệu ứng đám đông" và "sự tự tin thái quá"
Hiệu ứng đám đông là xu hướng tin vào những gì mà nhiều người khác tin, ngay cả khi không có bằng chứng xác thực. Trong cá cược bóng đá, hiệu ứng đám đông có thể khiến bạn đặt cược vào một đội chỉ vì nhiều người khác đang đặt cược vào đội đó, mà không cần phân tích kỹ lưỡng.
Sự tự tin thái quá là xu hướng đánh giá quá cao khả năng của bản thân. Trong cá cược bóng đá, sự tự tin thái quá có thể khiến bạn đặt cược lớn hơn, bỏ qua những rủi ro, và không chịu học hỏi từ những sai lầm.
Để tránh những bẫy tâm lý này, bạn cần phải có một tư duy độc lập, không bị ảnh hưởng bởi ý kiến của người khác, và luôn khiêm tốn học hỏi.
Đặt cược theo cảm tính và thiếu kiến thức
Đặt cược theo cảm tính là đặt cược dựa trên cảm xúc, chứ không phải dựa trên phân tích và thông tin. Ví dụ, bạn có thể đặt cược vào đội bóng yêu thích của mình chỉ vì bạn thích đội đó, mà không cần quan tâm đến khả năng thắng của đội.
Thiếu kiến thức là không có đủ thông tin và hiểu biết về bóng đá, về các đội bóng, về các loại kèo, và về các yếu tố ảnh hưởng đến kết quả trận đấu.
Để tránh những sai lầm này, bạn cần phải luôn đặt cược dựa trên phân tích và thông tin, chứ không phải dựa trên cảm xúc. Bạn cũng cần phải liên tục học hỏi và nâng cao kiến thức của mình về bóng đá.
Quá tin tưởng vào các "tip" và "dự đoán" từ nguồn không uy tín
Có rất nhiều trang web và cá nhân rao bán "tip" và "dự đoán" bóng đá. Tuy nhiên, phần lớn trong số này là lừa đảo hoặc không đáng tin cậy.
Để tránh bị lừa đảo, bạn cần phải cẩn thận với những lời quảng cáo hoa mỹ và những kèo cược "chắc chắn thắng". Hãy tìm hiểu kỹ về nguồn cung cấp thông tin trước khi tin tưởng, và không nên chỉ dựa vào "tip" và "dự đoán" để đưa ra quyết định.
Kết luận

Cá cược bóng đá không chỉ là về kiến thức và kỹ năng phân tích, mà còn là về kiểm soát tâm lý và quản lý vốn một cách thông minh. Nếu bạn không thể kiểm soát được cảm xúc của mình và không biết cách quản lý tiền bạc một cách hợp lý, bạn sẽ rất dễ thua lỗ.
Kiểm soát cảm xúc - Chìa khóa để không bị "cuốn" vào vòng xoáy cá cược
Cảm xúc là kẻ thù lớn nhất của người chơi cá cược. Tham lam, sợ hãi, thất vọng, tất cả đều có thể dẫn đến những quyết định sai lầm. Khi thắng, bạn có thể trở nên tự tin thái quá và mạo hiểm hơn. Khi thua, bạn có thể cố gắng gỡ gạc và đặt cược lớn hơn, dẫn đến thua lỗ nặng nề hơn.
Để kiểm soát cảm xúc, bạn cần phải có một mục tiêu rõ ràng, một kế hoạch cá cược cụ thể, và tuân thủ nó một cách nghiêm ngặt. Đừng bao giờ đặt cược nhiều hơn số tiền bạn có thể chấp nhận mất. Đừng bao giờ cố gắng gỡ gạc bằng cách đặt cược lớn hơn. Và đừng bao giờ để cảm xúc chi phối quyết định của bạn.
Hãy nhớ rằng cá cược chỉ là một trò chơi giải trí, đừng để nó ảnh hưởng đến cuộc sống và các mối quan hệ của bạn.
Quản lý vốn khoa học - Bài toán sinh tồn trong thế giới cá cược
Quản lý vốn là yếu tố then chốt quyết định sự thành bại của người chơi cá cược. Ngay cả khi bạn có kiến thức và kỹ năng phân tích tốt, nếu bạn không biết cách quản lý tiền bạc một cách hợp lý, bạn cũng sẽ rất dễ thua lỗ.
Có rất nhiều phương pháp quản lý vốn khác nhau, nhưng một nguyên tắc cơ bản là bạn nên chia nhỏ số vốn của mình thành nhiều phần nhỏ, và chỉ đặt cược một phần nhỏ của tổng vốn cho mỗi trận đấu. Điều này giúp bạn giảm thiểu rủi ro và kéo dài thời gian chơi.
Bạn cũng nên đặt ra một giới hạn thua lỗ cho mỗi ngày, mỗi tuần, hoặc mỗi tháng. Nếu bạn đạt đến giới hạn đó, hãy dừng lại và không đặt cược nữa. Đừng bao giờ cố gắng gỡ gạc bằng cách đặt cược lớn hơn, vì điều đó chỉ làm tình hình trở nên tồi tệ hơn.
Phân tích tỷ lệ cược và giá trị kỳ vọng (Expected Value - EV)
Khái niệm "giá trị kỳ vọng" (EV) là một công cụ quan trọng để đánh giá xem một kèo cược có đáng để đặt hay không. EV được tính bằng cách nhân xác suất thắng với số tiền thắng cược tiềm năng, sau đó trừ đi xác suất thua nhân với số tiền thua cược tiềm năng.
Nếu EV lớn hơn 0, kèo cược đó có giá trị dương và đáng để đặt. Nếu EV nhỏ hơn 0, kèo cược đó có giá trị âm và không nên đặt.
Tuy nhiên, việc tính toán EV không phải lúc nào cũng dễ dàng, vì bạn cần phải ước tính được xác suất thắng thua một cách chính xác. Điều này đòi hỏi bạn phải có kiến thức và kinh nghiệm sâu rộng về bóng đá.
Ứng Dụng Các Công Cụ và Nguồn Thông Tin Hỗ Trợ Soi Kèo

Trong thế giới cá cược bóng đá đầy sôi động và kịch tính, việc nắm vững luck8 có lừa đảo không là bước đầu tiên và quan trọng nhất để có thể đưa ra những quyết định đặt cược thông minh.
Giải mã các loại kèo phổ biến: Kèo Châu Á, Châu Âu và Tài Xỉu
Kèo Châu Á (hay còn gọi là kèo chấp) là loại kèo phổ biến bậc nhất, đặc biệt trong các trận đấu mà có sự chênh lệch về trình độ giữa hai đội. Kèo Châu Á bao gồm kèo chấp bóng (ví dụ: chấp 0.25, 0.5, 0.75 bàn) và kèo tài xỉu (dự đoán tổng số bàn thắng trong trận đấu nhiều hơn hay ít hơn một con số nhất định). Khi đọc kèo Châu Á, bạn cần chú ý đến đội được chấp (đội cửa dưới) và đội chấp (đội cửa trên), cũng như tỷ lệ ăn tiền của mỗi đội. Ví dụ, kèo chấp 0.5 có nghĩa là đội cửa trên phải thắng cách biệt ít nhất 1 bàn thì người đặt cược mới thắng tiền.
Kèo Châu Âu (hay kèo 1X2) đơn giản hơn nhiều, chỉ có ba lựa chọn: đội nhà thắng (1), hòa (X) hoặc đội khách thắng (2). Tỷ lệ kèo Châu Âu thường được biểu thị dưới dạng số thập phân, và bạn chỉ cần nhân số tiền đặt cược với tỷ lệ kèo để tính ra số tiền thắng cược tiềm năng.
Kèo Tài Xỉu là loại kèo dự đoán tổng số bàn thắng ghi được trong một trận đấu, không quan trọng đội nào thắng hay thua. Nhà cái sẽ đưa ra một con số, và người chơi sẽ đặt cược vào Tài (tổng số bàn thắng nhiều hơn con số đó) hoặc Xỉu (tổng số bàn thắng ít hơn con số đó).
Việc nắm vững cách đọc và hiểu các loại kèo này là nền tảng để bạn có thể phân tích và đưa ra những dự đoán chính xác hơn.
Cách nhà cái thiết lập tỷ lệ kèo và yếu tố ảnh hưởng
Nhà cái không đơn thuần dựa vào may rủi để thiết lập tỷ lệ kèo đóng vai trò then chốt, quyết định sự thành bại của người chơi. Hiểu rõ về các loại kèo, cách nhà cái ra kèo, và những yếu tố ảnh hưởng đến tỷ lệ sẽ giúp bạn đưa ra những quyết định sáng suốt, tối ưu hóa lợi nhuận và giảm thiểu rủi ro. Bài viết này sẽ đi sâu vào phân tích chi tiết về luck8 có lừa đảo không. Họ sử dụng một hệ thống phức tạp, kết hợp các thuật toán, thống kê, và đánh giá chuyên môn để đưa ra tỷ lệ kèo phản ánh xác suất xảy ra của các kết quả khác nhau.
Các yếu tố ảnh hưởng đến tỷ lệ kèo bao gồm: phong độ hiện tại của các đội, lịch sử đối đầu, đội hình ra sân (có cầu thủ chủ chốt nào bị chấn thương hay treo giò không), sân nhà, điều kiện thời tiết, v.v. Thậm chí, những tin đồn xung quanh đội bóng cũng có thể tác động đến tỷ lệ kèo.
Tìm hiểu thêm
tải game 123bNhà cái cũng điều chỉnh tỷ lệ kèo liên tục để phản ánh những thay đổi thông tin và sự biến động trong thị trường cá cược. Do đó, việc theo dõi và cập nhật thông tin liên tục là rất quan trọng.
Phân tích biến động kèo và dấu hiệu nhận biết kèo "thơm"
Biến động kèo là hiện tượng tỷ lệ kèo thay đổi liên tục theo thời gian, phản ánh sự thay đổi trong đánh giá của thị trường về khả năng xảy ra của các kết quả khác nhau. Phân tích biến động kèo có thể giúp bạn nhận biết những cơ hội cá cược tiềm năng.
Ví dụ, nếu tỷ lệ kèo chấp của một đội giảm xuống đáng kể, điều đó có thể cho thấy rằng có nhiều người đặt cược vào đội đó, có thể là do những thông tin mới về tình hình lực lượng hoặc chiến thuật của đội. Ngược lại, nếu tỷ lệ kèo tăng lên, điều đó có thể cho thấy rằng ít người tin vào khả năng thắng của đội đó.
Kèo "thơm" là những kèo có tỷ lệ thắng cao hơn so với xác suất thực tế của sự kiện. Để nhận biết kèo "thơm", bạn cần phải có kiến thức sâu rộng về bóng đá, khả năng phân tích thông tin tốt, và kinh nghiệm cá cược. Đồng thời, bạn cũng cần phải theo dõi biến động kèo một cách cẩn thận và so sánh tỷ lệ kèo giữa các nhà cái khác nhau.
Tìm hiểu thêm
slot game mu88Tâm Lý Cá Cược và Quản Lý Vốn Hiệu Quả

Nắm vững luck8 có lừa đảo không







